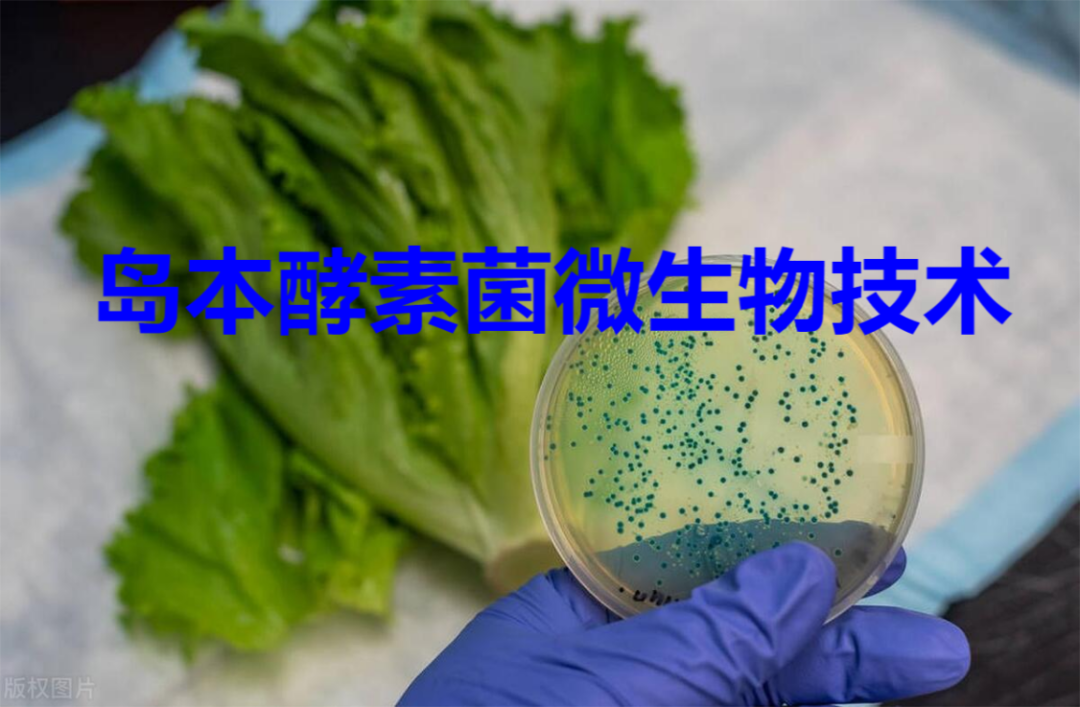

解决重茬问题的钥匙——岛本酵素菌复合微生物技术
来源: 发布时间:2024-07-22 返回列表
大棚种植的农户们常常会遇到重茬问题,导致减产严重。尽管他们尝试了各种方法,但始终未能找到有效的解决方案,除了搁置(浪费资源)就是换成无土栽培,给农户带来了严重的困扰。其实,有一个简单的方法可以克服重茬障碍,但许多农户对此表示怀疑,今天我们就来看看效果。

大棚重茬问题主要有三个原因:
第一,长期不良的用肥施肥习惯。仍然有很多农户过于依赖氮磷钾肥,而忽略了其他中微量元素和微生物菌剂的补充。虽然土壤中含有的元素较为丰富,但随着同一种蔬菜的连续种植,土壤养分不断被消耗,而得不到相应的补充,导致土壤某些元素缺失,自我修复能力变差,进而影响作物的正常生长。第二,蔬菜根系分泌的自毒物质。重茬种植会分泌一些有机酸和自毒物质,抑制蔬菜的健康生长。随着连续种植,土壤中的有机质含量也会逐渐减少,对下一茬蔬菜的生长造成严重影响。严重时甚至会出现死苗死棵的情况,直接导致产量下降。
第三,土壤微生态失衡。重茬种植同一种作物,使得一些适应的微生物大量滋生,有土壤微生态被破坏,自我修复能力变差,无法有效地分解土壤中存在的一些有害物质,使得土传病害加重。
针对以上问题,农户尝试使用杀菌剂来快速改善,治标不治本,采用有机肥、微生物菌剂等来改善土壤质量,效果不佳。而岛本酵素菌微生物技术的应用则为解决重茬问题提供了一个既生态环保又快速有效的方案。
原理:酵素菌微生物技术是利用复合酵素微生物菌群制作的酵素菌原液、酵素菌功能肥和酵素菌堆肥等。通过向土壤中添加适量的岛本酵素菌肥,可以有效改善土壤结构、增加土壤有机质含量、促进土壤微生物的繁殖,从而为蔬菜生长创造一个良好的环境。同时,岛本酵素菌还能分解有害物质,抑制病原菌的生长,减少土传病害的发生。这一技术的应用不仅有助于提高蔬菜的产量和品质,还能降低农户的生产成本,实现绿色可持续的农业生产。
虽然采用岛本酵素菌微生物技术的方法简单有效,但是很多农户还是不太敢尝试。因为一旦出现重茬问题,到时再解决为时已晚,农户们往往面临很大的损失。为了具体说明酵素菌微生物技术在解决重茬问题方面的效果,我们选取了部分案例进行分析:
案例一:甘肃半夏重茬问题
甘肃是我国半夏的主产区之一。然而,连续多年重茬种植导致土壤板结、养分失衡、半夏病虫害严重等问题。甘肃省农科院为帮助农户解决此类问题,通过尝试使用岛本酵素菌微生物技术进行土壤改良和作物防护。经过实践,土壤结构得到改善,养分含量提高,病虫害得到有效控制,半夏产量和品质均有所提升。

案例二:大棚蔬菜重茬问题
寿光一大棚蔬菜基地连续多年种植番茄,导致土壤盐渍化、病虫害积累等问题。农户采用岛本酵素菌微生物技术进行解决。经过一段时间的实践,土壤盐渍化程度降低,养分含量提高,青枯、脐腐病等病害得到有效控制,西红柿品质得到有效改善。

案例三:谷子重茬种植问题
谷子不宜重茬种植,陕西榆林一地区重茬种植谷子,出现病害多、减产严重等问题。当地农户采用岛本酵素菌肥进行重茬土壤改良。只经过一茬时间,重茬病害得到有效控制,谷子健壮,产量和品质均有所提升。

类似以上的案例还有很多,随着岛本酵素菌技术的应用与推广,种植难题将得到有效解决。为了进一步推广这一技术,我们将加强宣传力度、提供技术支持、扶持示范户、建立合作机制等措施,让更多的农户了解并掌握这一解决方案,以期推动我国农业的绿色可持续发展,为实现乡村振兴战略贡献力量。
岛本酵素:中国酵素农业发起人,酵农科技体系建设者!
END
版权声明:本文系潍坊岛本微生物技术研究所原创文章,版权所有,如需转载须注明出处!

鲁公网安备37070502000658号